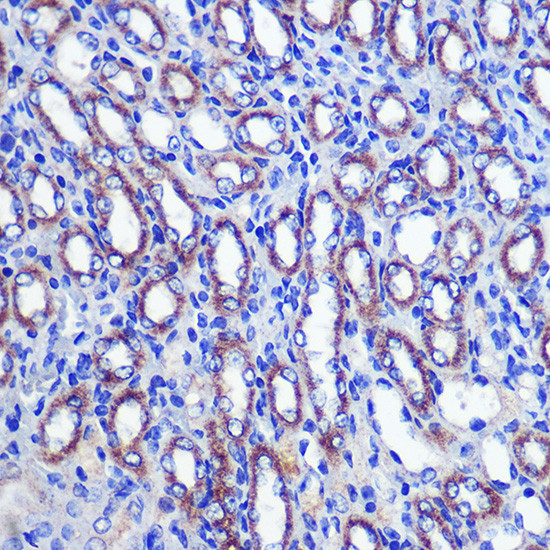
LETMD1 Antibody in Immunohistochemistry (Paraffin) (IHC (P))

Search
Invitrogen
LETMD1 Polyclonal Antibody
{{$productOrderCtrl.translations['antibody.pdp.commerceCard.promotion.promotions']}}
{{$productOrderCtrl.translations['antibody.pdp.commerceCard.promotion.viewpromo']}}
{{$productOrderCtrl.translations['antibody.pdp.commerceCard.promotion.promocode']}}: {{promo.promoCode}} {{promo.promoTitle}} {{promo.promoDescription}}. {{$productOrderCtrl.translations['antibody.pdp.commerceCard.promotion.learnmore']}}
图: 1 / 4
LETMD1 Antibody (PA5-96069) in IHC (P)




Please note: We are reviewing Western blot images included in the antibody testing data in our catalog, including those provided by third parties. Unless expressly labeled or annotated as “raw-unedited”, Western blot images included in the antibody testing data in our catalog may have been edited, optimized or otherwise adjusted for presentation.
产品信息
PA5-96069
种属反应
宿主/亚型
分类
类型
抗原
偶联物
形式
浓度
规格
纯化类型
保存液
内含物
保存条件
运输条件
RRID
产品详细信息
Immunogen sequence: FPRQLLIRHF WTPKQQTDFL DIYHAFRKQS HPEIISYLEK VIPLISDAGL RWRLTDLCTK IQRGTHPAIH DILALRECFS NHPLGMNQLQ ALHVKALSRA MLLTSYLPPP LLRHRLKTHT TVIHQLDKAL AKLGIGQLTA QEVKSACYLR GLNSTHIGED RCRTWLGEWL QISCSLKEAE LSLLLHNVVL LSTNYLGTRR; Positive Samples: MCF7, Mouse liver; Cellular Location: Mitochondrion outer membrane, Single-pass membrane protein
靶标信息
HCCR-1 (human cervical cancer oncogene 1), also known as HCCR-2 or LETMD1, is a 360 amino acid single-pass membrane protein that is expressed in the kidney, liver, skeletal muscle, heart and brain. It is suggested that HCCR-1 may be involved in tumorigenesis and may function as a negative regulator of the p53 tumor suppressor. Overexpression of HCCR-1 may cause mitochondrial dysfunction that can lead to UVC or staurosporine-induced apoptosis resistance and progression of tumor formation. HCCR-1 is considered a candidate biomarker for breast cancer. Various human tumors including leukemia, lymphoma, and carcinomas of the breast, kidney, ovary, stomach, colon, and uterine cervix have high HCCR-1. Six isoforms exist due to alternative splicing events.
仅用于科研。不用于诊断过程。未经明确授权不得转售。
篇参考文献 (0)
生物信息学
蛋白别名: Cervical cancer receptor; LETM1 domain-containing protein 1; MCC-32
基因别名: 1110019O13Rik; AI593524; BB130465; BB235638; HCCR-2; HCCR1; Letmd1; MCC-32; Mccr; RGD1310591
UniProt ID: (Mouse) Q924L1
Entrez Gene ID: (Mouse) 68614, (Rat) 681352